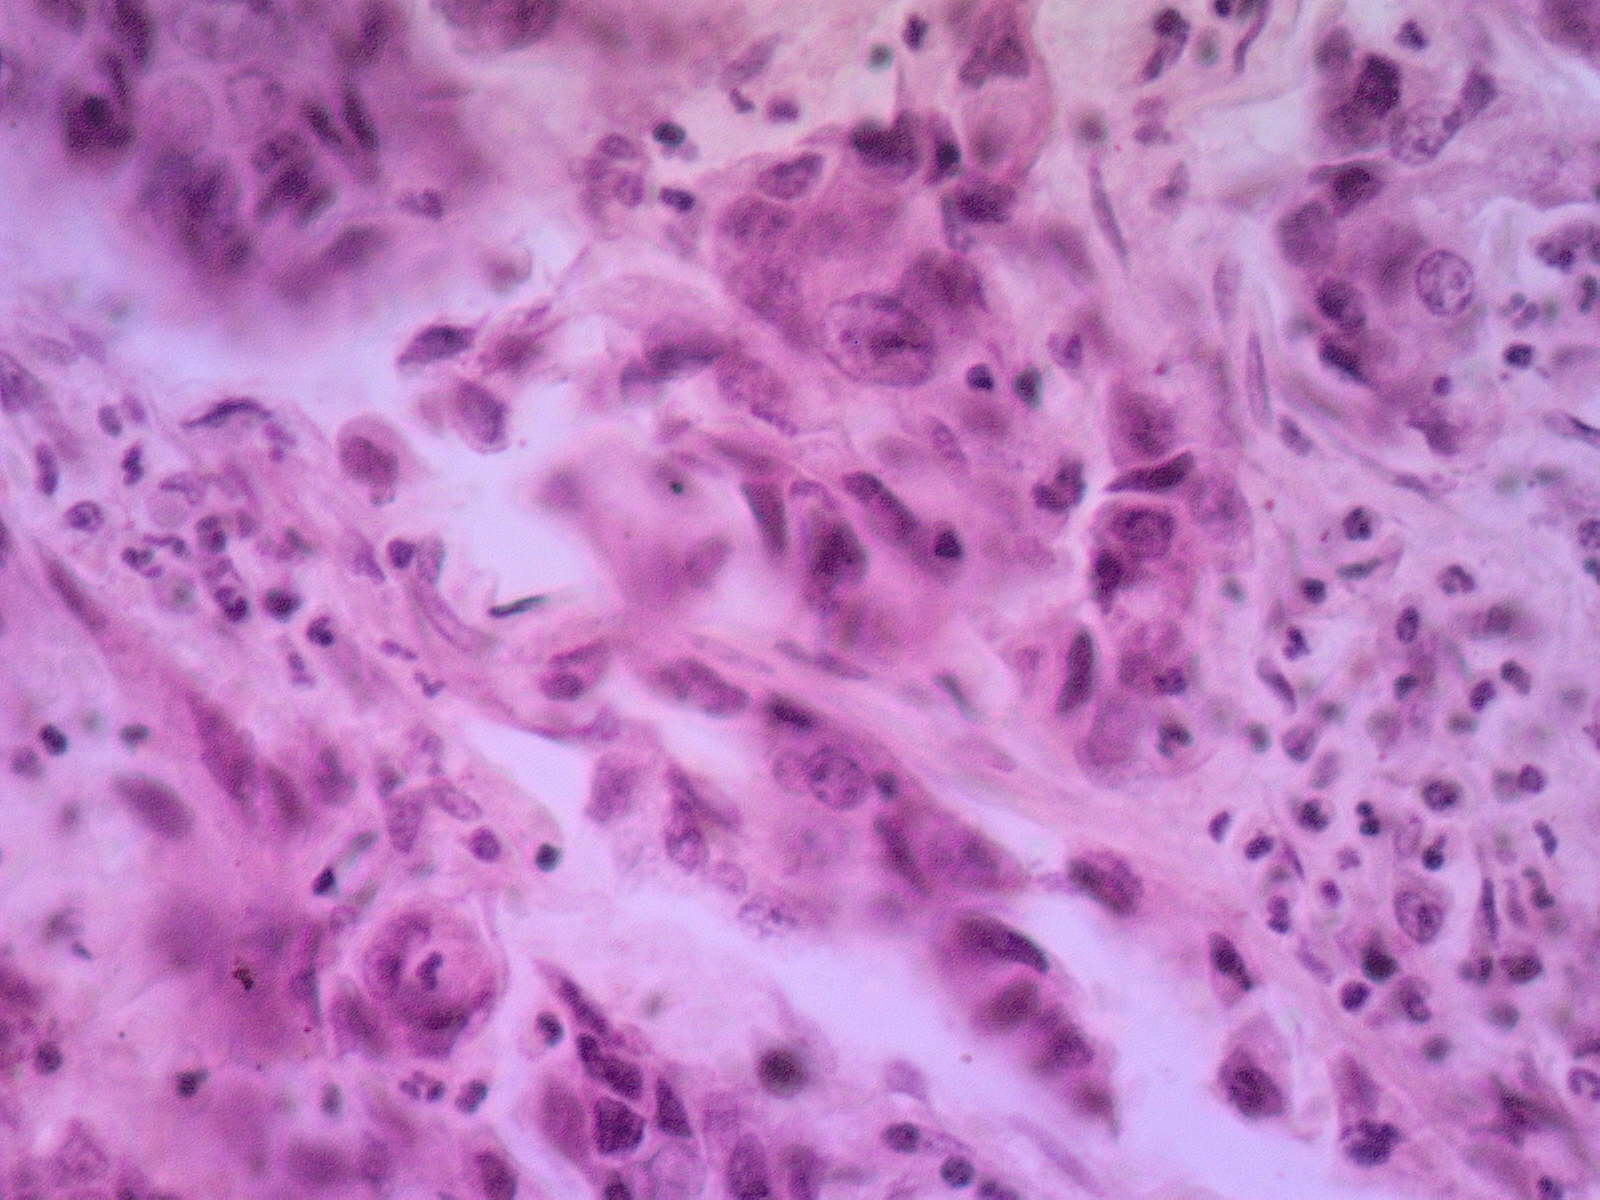

Материал: Задание+20.+Болезни+ЖКТ-1
ФГБОУ ВО «УРАЛЬСКИЙ ГОСУДАРСТВЕННЫЙ МЕДИЦИНСКИЙ УНИВЕРСИТЕТ»
Министерства здравоохранения Российской Федерации
Кафедра патологической анатомии и судебной медицины
«Утверждаю»
Заведующий кафедрой
Д.м.н., проф. ____________ Л.М. Гринберг
«____» ______________________ 20___ год
МЕТОДИЧЕСКАЯ РАЗРАБОТКА К ПРАКТИЧЕСКОМУ ЗАНЯТИЮ
(для студентов)
ООП специальности 31.05.02 «Педиатрия»
Дисциплина Б1.Б.22 «Патологическая анатомия, клиническая патологическая анатомия»
ТЕМА ЗАНЯТИЯ: ПАТОЛОГИЯ СЛЮННЫХ ЖЕЛЕЗ, ПИЩЕВОДА И ЖЕЛУДКА. ХРОНИЧЕСКИЙ ГАСТРИТ. ЯЗВЕННАЯ БОЛЕЗНЬ. ОПУХОЛИ СЛЮННЫХ ЖЕЛЕЗ, ПИЩЕВОДА И ЖЕЛУДКА.
УЧЕБНАЯ ЦЕЛЬ ЗАНЯТИЯ: изучение этиологии, пато- и морфогенеза, морфологической сущности острых воспалительных заболеваний пищевода, желудка; изучение принципов классификации, терминологии и нозологической принадлежности эзофагитов, хронических гастритов, язвенной болезни; составление представления о широте распространения и значимости заболеваний желудочно-кишечного тракта, факторов риска и условиях их реализации. Составление представления об опухолевых процессах пищевода и желудка.
ЗАДАЧИ ЗАНЯТИЯ:
По окончании занятия студент должен знать:
- принципы классификации эзофагитов, гастритов, их терминологию и нозологическую принадлежность;
- макро- и микроскопическую характеристику воспалительных и опухолевых заболеваний желудочно-кишечного тракта;
- возможные исходы и осложнения заболеваний желудочно-кишечного тракта.
Студент должен уметь:
- диагностировать острые воспалительные заболевания слюнных желез, пищевода, желудка;
- проводить дифференциальную диагностику воспалительных и опухолевых заболеваний слюнных желез, пищевода и желудка;
- устанавливать нозологическую принадлежность в конкретных клинических ситуациях.
шифр |
Содержание компетенции |
знать |
уметь |
владеть |
ОК-1 |
способностью к абстрактному мышлению, анализу, синтезу |
- определение, механизмы развития, разновидности: причины, пато- и морфогенез, этиологию, патоморфоз, принципы классификации клинико-морфологическая характеристику, методы диагностики, исходы различных болезней слюнных желез, пищевода и желудка ОК- 1,4,7,8 ПК - 15, 16, 17, 18
|
- работать с увеличительной техникой (микроскоп); - оценить гистофизиологическое состояние основных клеточных, тканевых и органных структур организма при различных болезнях слюнных желез, пищевода и желудка; - описывать морфологические изменения изучаемых макроскопических, микроскопических препаратов и электроннограмм при различных болезнях пищевода и желудка; - описывать морфологические изменения изучаемых макроскопических, микроскопических препаратов и электроннограмм при различных болезнях пищевода и желудка - дифференцировать на микро и макро препаратах различные болезни пищеварительной системы ОК- 1,4,7,8 ПК - 3, 6, 15, 16, 17, 18, 20, 34, 36
|
- медико-функциональным понятийным аппаратом по вопросам различных болезней пищеварительной системы; - методами исследования биопсийного и операционного материала при различных болезнях слюнных желез, пищевода и желудка ОК- 1,4,7,8 ПК - 3, 6 |
ОК- 2 |
способностью использовать основы философских знаний для формирования мировоззренческой позиции |
|||
ОК- 5 |
готовностью к саморазвитию, самореализации, самообразованию, использованию творческого потенциала |
|||
ОК-8 |
готовностью к работе в коллективе, толерантно воспринимать социальные, этнические, конфессиональные и культурные различия |
|||
ОПК-1 |
готовностью решать стандартные задачи профессиональной деятельности с использованием информационных, библиографических ресурсов, медико-биологической терминологии, информационно-коммуникационных технологий и учетом основных требований информационной безопасности |
|||
ОПК-3 |
способностью использовать основы экономических и правовых знаний в профессиональной деятельности |
|||
ОПК-4 |
способностью и готовностью реализовать этические и деонтологические принципы в профессиональной деятельности |
|||
ОПК- 6 |
готовностью к ведению медицинской документации |
|||
ОПК-9 |
способностью к оценке морфофункциональных, физиологических состояний и патологических процессов в организме человека для решения профессиональных задач |
|||
ПК-5 |
готовностью к сбору и анализу жалоб пациента, данных его анамнеза, результатов осмотра, лабораторных, инструментальных, патолого-анатомических и иных исследований в целях распознавания состояния или установления факта наличия или отсутствия заболевания |
|||
ПК-6 |
способностью к определению у пациентов основных патологических состояний, симптомов, синдромов заболеваний, нозологических форм в соответствии с Международной статистической классификацией болезней и проблем, связанных со здоровьем - X пересмотр, принятой 43-ей Всемирной Ассамблеей Здравоохранения, г. Женева, 1989 г. |
|||
ОК-1 |
способностью к абстрактному мышлению, анализу, синтезу |
|||
ОК- 2 |
способностью использовать основы философских знаний для формирования мировоззренческой позиции |
|||
ОК- 5 |
готовностью к саморазвитию, самореализации, самообразованию, использованию творческого потенциала |
ПРОДОЛЖИТЕЛЬНОСТЬ ЗАНЯТИЯ: 2 часа
Для успешной работы на практическом занятии необходимо:
5.1 Проработать тренировочные тесты по теме занятия на сайте кафедры.
5.2 Диагностировать микропрепараты по теме занятия на сайте кафедры.
5.3. Знать теоретический материал:
Определение и принципы классификации заболевания желудочно-кишечноготракта;
Патологическая анатомия болезней слюнных желез (пороки развития, воспалительные – сиалоадениты, дистрофические – сиалолитиаз, опухоли),
Нозологическая принадлежность и место в структуре диагноза острого и хронического эзофагитов, осложнения, исходы;
Опухолевые заболевания пищевода: классификации, морфологические особенности;
Определение и принципы классификации заболеваний желудка;
Виды хронических гастритов, особенности этиологии, патогенеза и морфологических характеристик;
Этиология, патогенез, патологическая анатомия, осложнения и исходы язвенной болезни желудка и 12-перстной кишки;
Опухолевые заболевания желудка и 12-перстной кишки: классификации, морфологические особенности
6. ЗАДАНИЯ И МЕТОДИЧЕСКИЕ УКАЗАНИЯ К ИХ ВЫПОЛНЕНИЮ
На занятии студенту необходимо выполнить:
6.1. Ответить на входного тест-контроля
6.2. Ответить на вопросы преподавателя
6.3. Принять участие в обсуждении
6.4. Изучить таблицы: 57 – вторичные изменения в опухолях; 58 – предопухолевые процессы с переходом в рак; 62 – опухоли эпетелиального происхождения (злокачественные); 63 – опухоли эпетелиального происхождения (злокачественные)
6.5. Описать по схеме и сделать заключение по макропрепаратам: 209/210, 2/4, 295/297. Сделать заключение: 2/3,298, 308/309/310, 358/359, 343/340.
6.6. Изучить, зарисовать и отметить существенные элементы на микропрепаратах: 99, 200. Изучить: 96, 100, 195.
№ 96. Плоскоклеточный ороговевающий рак пищевода
В пищеводе неороговевающий многослойный плоский эпителий расположен на базальной мембране. Раковые разрастания из этого эпителия в виде тяжей и пластов различной формы и величины проникают в подмышечный и мышечный слои. В глубине опухолевых пластов видны розового цвета ороговевающие клетки, которые формируют концентрические структуры. Это раковые «жемчужины». На большем увеличении отмечается клеточный и ядерный полиморфизм, а также фигуры деления ядер. Вокруг опухоли густая лимфоидноклеточная инфильтрация.
Существенные элементы: 1. тяжи раковых клеток
2. раковые «жемчужины»
3. лимфоидноклеточные инфильтраты

№ 99. Аденокарцинома пилоруса
В пилорическом отделе желудка, кроме слизистой оболочки обычной структуры, видны разрастания опухоли железистого строения. Железы полиморфные. Они различны по величине и форме, распределены в строме неравномерно. На большем увеличении — эпителий опухолевых желез полиморфный, располагается хаотично, иногда в несколько рядов, полярность клеток нарушена, ядра гипер- и гипохромные, большие, встречаются различные фигуры деления ядер (митозы).
Существенные элементы: 1. полиморфные железы
2. полиморфный эпителий
3. полиморфные ядра
4. митозы

№ 100. Перстневидноклеточная карцинома (гастробиоптат)
В гастробиоптате определяются железы желудка обычного строения. Рядом расположены островки и поля крупных клеток со светлой цитоплазмой и ядром, оттесненным капелькой слизи на периферию («перстневидные клетки»).
Существенные элементы: 1. железы желудка
2. перстневидные опухолевые клетки

№ 195. Катаральный гастрит
Окраска по Мейеру.
В гистопрепарате срез желудка. Четко видны все слои желудка. Слизистая оболочка утолщена, отечна. Выявляется дистрофия, некробиоз и слущивание эпителия. Эти цветки отличаются повышенным слизеобразованием. Поверхность слизистой оболочки обильно покрыта слизистыми массами (при данной окраске слизь имеет малиновый цвет). Сосуды полнокровные, определяются множественные мелкие кровоизлияния и круглоклеточные инфильтраты.
Существенные элементы: 1. отечная слизистая оболочка
2. полнокровие
3. слизистые массы


№ 200. Хроническая язва желудка в период обострения Визуально в стенке желудка определяется язвенный дефект. На малом увеличении в дне язвы отмечается широкая зона фибриноидного некроза с воспалительной клеточной инфильтрацией. За зоной некроза располагается слой грануляционной ткани с большим количеством сосудов. Самый глубокий слой представлен пучками и тяжами зрелой соединительной ткани с участками гиалиноза. Встречаются сосуды с резко утолщенными стенками и разросшиеся нервные волокна по типу невром.
Существенные элементы: 1. гнойно-некротический слой
2. слой грануляционной ткани
3. слой зрелой соединительной ткани
4. склерозированные стенки сосудов
5. разросшиеся нервные волокна




6.7. ОЦЕНИВАНИЕ ЗНАНИЙ, УМЕНИЙ, НАВЫКОВ ПО ТЕМЕ ЗАНЯТИЯ
ПРАКТИЧЕСКОЕ ЗАНЯТИЕ – max 2,5 балла:
за тест: 1 б. – оц.-5; 0,7 б. – оц.-4; 0,5б. – оц.-3.
за устный ответ: 1 б. – оц.-5; 0,7 б. – оц.-4; 0,5б. – оц.-3.
Отчет по практической части занятия, по лекции – 0,5 балла
УЧЕБНО-ИССЛЕДОВАТЕЛЬСКАЯ РАБОТА:
«Патоморфоз острой язвы желудка»
«Перстневидный рак»
ЛИТЕРАТУРА ДЛЯ ПОДГОТОВКИ К ЗАНЯТИЮ:
Основная:
Лекционный материал
Патология. Под редакцией М.А. Пальцева. – М: «Медицина». – 2017. – В 2 томах.
Зайратьянц О.В. Патологическая анатомия. Атлас
Дополнительная:
учебник «Патологическая анатомия», 2017, Т.2, часть 1,
9. Методическая разработка подготовлена доцентом, к.м.н. А.С. Филатовой
Обсуждена на заседании кафедры № ____ от «___» _______________ 20___ г.